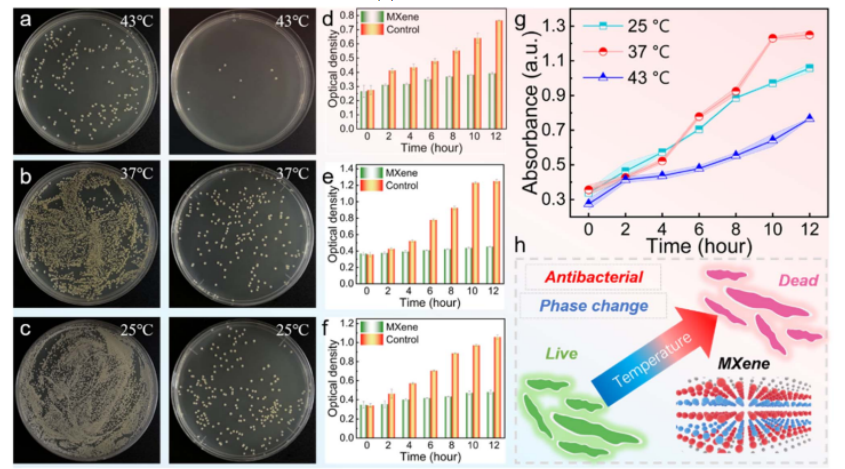

隨著便攜式設備的快速發展,人們需要具有長期穩定性、安全性和舒適性的復合材料。然而,在電磁干擾(EMI)屏蔽、熱管理和抗菌性能方面,單一復合材料實現穩定性、安全性和舒適性具有挑戰性。在本研究中,我們開發了一系列具有MXene層和相變層的層狀非對稱多功能pcc。非對稱結構可將電磁屏蔽效率調節至54.5 dB,并提高光熱/磁熱轉換,協助PCCs維持相當的溫度。由于MXene@PDA具有更好的結構和化學穩定性,在較高的溫度下表現出較高的抗菌活性,因此PCCs具有巨大的抗菌應用潛力。總之,我們的工作為通過非對稱設計制造先進的復合材料提供了新的見解,所獲得的PCCs在EMI屏蔽和無線個人熱治療方面顯示出重要的應用潛力
.png)
圖1. 復合相變膜的多功能性和性能。

圖2. Schematic diagram for the preparation of the asymmetric phase change composite.

圖3. (a) MXene合成圖解。(b)所得MXene的XRD表征。(c)獲得的MXene的AFM表征。(d)所得MXene分散液的廷德爾效應。(e) MXene@PDA層的表面。(f)數字照片和(g) MXene-Fresh和MXene-2W的XRD圖案。(h) MXene@PDA-Fresh和MXene@PDA-2W薄膜的XRD圖案。

圖4. (a)不同NaCl含量的水蝕刻泡沫和pda涂層泡沫的圖像。(b)不同NaCl含量的水蝕刻的NaCl分數。(c) EE和PEE的FTIR光譜。EE和PEE的接觸角試驗。(e) EE和(f) PEE的SEM圖像。(g) PEE的靈活性。

圖5. (a) peg浸漬的EE泡沫和(b) PPEE的SEM圖像。(c) PDA涂覆前后的PEG吸收率比較。(d) MPPE的SEM圖像。(e) MPPE的EDS表征。(f)不同MXene厚度的MPPE的電導率。

圖6 (a) x波段不同入射EMWs和MXene厚度的屏蔽電磁干擾曲線。(b)不同入射EMWs和MXene厚度的pcc的平均SET。(c)不同入射EMWs和MXene厚度的PCCs的平均SER。(d)不同入射EMWs和MXene厚度的PCCs的平均SEA。(e)透過不同入射EMW的MPPE之EMW透過率過程圖解。(f)不同入射EMWs和MXene厚度下的T、R和A參數。(g)不同填充比例的電磁干擾屏蔽效率比較。

圖7 (a)光熱轉換的設置和溫度監測。(b) MPPE-40的UV-vis-IR透射率。(c) mpe -40的UV-vis-IR反射率。(d)通過具有不同入射光的MPPE的光透射過程的圖解。(e)光從MXene層入射的MPPE的溫度分布。(f)光從PPEE層入射時MPPE的溫度分布。(g)不同入射光下的上表面最高溫度曲線。(h)不同入射光側表面的平均溫度曲線。

圖8 (a)熱療應用中磁-熱轉換的圖示。(b) 2.5、4.8、9.0、12.4 a電流下PCC的實時圖像(c) 2.5、4.8、9.0、12.4 a電流下PCC的溫度曲線(d) PCC的充電和溫度維持性能。
圖9對照(左)和MXene(右)組在不同溫度(a) 43℃、(b) 37℃和(C) 25℃下對金黃色葡萄球菌的抗菌測試圖像。金黃色葡萄球菌在不同溫度下的OD再生數據:(d) 43°C, (e) 37°C, (f) 25°C。(g)不同溫度下金黃色葡萄球菌OD再生曲線的比較。(h)溫度和MXene的抗菌作用說明。
相關科研成果由華中科技大學能源轉化與儲存材料化學重點實驗室Jinping Qu和Xiang Lu等人于2023年發表在Journal of Materials Chemistry A(DOI: 10.1039/d3ta03184e)上。原文:Engineering asymmetric multifunctional phase change composites for improved electromagnetic interference shielding and wireless personal thermal therapy
原文鏈接:https://pubs.rsc.org/en/content/articlelanding/2023/TA/D3TA03184E。
轉自《石墨烯研究》公眾號